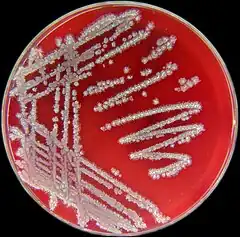
Description de l'image Bacillus licheniformis.jpg.

Bacillus licheniformis
| Domaine | Bacteria |
|---|---|
| Phylum | Bacillota |
| Classe | Bacilli |
| Ordre | Caryophanales |
| Famille | Bacillaceae |
| Genre | Bacillus |
Espèce
H. Weigmann 1898 - Frederick Dixon Chester 1901
Bacillus licheniformis est une bactérie commune du sol. Elle se retrouve aussi dans le plumage des oiseaux, particulièrement au niveau du ventre et de la queue, le plus souvent chez des oiseaux vivant près du sol (tels que les passereaux) et dans l'eau (tels que les canards)[1].
Il s'agit d'une bactérie gram positive thermophile. Sa température optimale de croissance se situe aux alentours de 50 °C mais elle peut survivre à des températures bien plus élevées. La température optimale pour la sécrétion d'enzymes se situe à 37 °C. Elle peut survivre sous forme de spores lorsqu'elle est confrontée à des environnements difficiles ou être dans un état végétatif lorsque les conditions sont favorables.
Actuellement, les scientifiques étudient son aptitude à dégrader les plumes pour des fins agricoles. Les plumes contiennent un taux élevé de protéines non-dégradables mais les chercheurs espèrent qu'au travers de la fermentation réalisée par B. licheniformis, les déchets de plumes pourront être recyclés afin de produire des farines nutritives et bon marché permettant de nourrir le bétail.
Des recherches en écologie tentent, quant à elle, de mettre en évidence une interaction entre les couleurs de plumage et l'activité de B. licheniformis ainsi que leurs conséquences[2]. Cette bactérie dégradant les plumes peut avoir joué un rôle important dans l'évolution de la mue et dans les schémas de coloration des plumes (règle de Gloger).
Lessive biologique
Bacillus licheniformis est cultivé afin d'obtenir des protéases utilisées dans les lessives biologiques. Cette bactérie est très bien adaptée aux milieux alcalins, dans lesquels elle peut croître, de sorte qu'elle produit des protéases pouvant résister à des pH élevés. Ceci en fait donc une bactérie idéale pour ces lessives puisque les autres composants participent à la création d'un environnement alcalin. Ces protéases ont un pH optimum compris entre 9 et 10 et sont ajoutées aux lessives de blanchisserie afin de digérer, et finalement d'éliminer les salissures faites de protéines. Ces lessives sont particulièrement bien adaptées aux lavages basses températures ce qui permet à la fois de faire des économies d'énergie mais aussi d'éviter les rétrécissements et les déteintes.
Applications en nanotechnologie
Bacillus licheniformis peut être utilisé dans la synthèse de nanotubes d'or[3]. Les chercheurs ont souvent besoin de synthétiser des nanoparticules d'or d'une taille comprises entre 10 et 100 nanomètres. Ces nanoparticules sont généralement synthétisées à haute température, à l'aide de solvants organiques et de réactifs toxiques. Les bactéries les produisent elles-mêmes dans des conditions plus clémentes.
Références
- ↑ (en) Williams CM, Richter CS, Mackenzie JM, Shih JC, « Isolation, identification, and characterization of a feather-degrading bacterium », Appl. Environ. Microbiol., vol. 56, no 6, , p. 1509-1515 (lire en ligne)
- ↑ (en) Goldstein G, Flory KR, Browne BA, Majid S, Ichida JM, Burtt HE, « Isolation, identification, and characterization of a feather-degrading bacterium », The Auk, vol. 121, no 3, , p. 656-659 (DOI 10.1642/0004-8038(2004)121[0656:BDOBAW]2.0.CO;2)
- ↑ (en) Microbial nanotechnologists, August 1, 2009
- (en) Cet article est partiellement ou en totalité issu de l’article de Wikipédia en anglais intitulé « Bacillus licheniformis » (voir la liste des auteurs).
Liens externes
- génome of Bacillus licheniformis ATCC14580 - publication
- (en) LPSN : Bacillus licheniformis (Weigmann 1898) Chester 1901 (Approved Lists 1980) (consulté le )
- Portail de la microbiologie